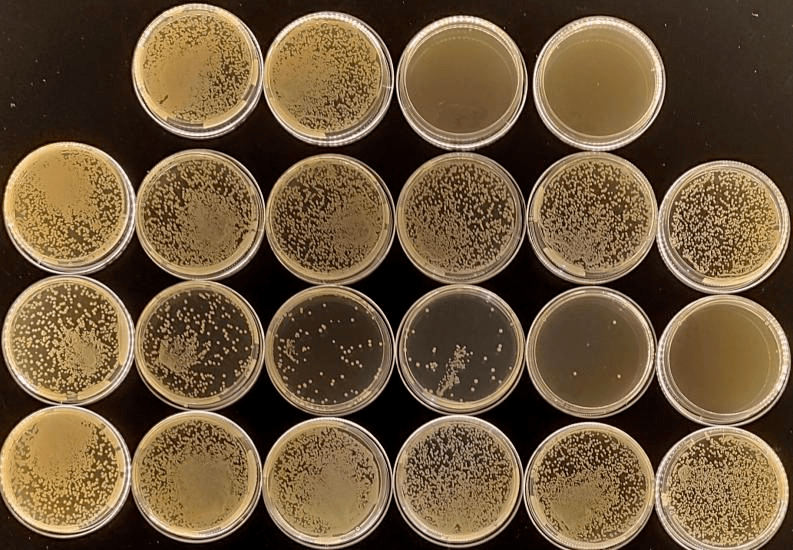
聚维酮碘戊二醛苯扎溴铵复合碘溶液这些水产常用消毒剂全池泼洒给药真

戊二醛分析纯

20210315rmb拍卖50分析纯戊二醛20ml3瓶
图片尺寸640x640
戊二醛
图片尺寸300x300
戊二醛
图片尺寸800x800
111308戊二醛
图片尺寸300x300
2020年通过戊二醛浸泡进行消毒灭菌的医疗器械其残留毒性如何评价
图片尺寸619x323
戊二醛(50%)
图片尺寸800x800
优惠 戊二醛
图片尺寸710x532
【赛为】20%浓戊二醛消毒剂 兽药 畜禽养殖广谱杀灭病毒细菌 猪流感
图片尺寸750x787
g810413 戊二醛(50%), ar,50% in h2o
图片尺寸200x180
供应戊二醛 工业戊二醛消毒液 医药级戊二醛厂家
图片尺寸600x600
利尔康2%强化戊二醛消毒液牙科器械工具医院用消毒水鱼缸除黑毛藻
图片尺寸790x993
利尔康2%强化戊二醛消毒剂(2000ml) 器械消毒液医院 器械浸泡
图片尺寸751x751
【赛为】20%浓戊二醛消毒剂 兽药 畜禽养殖广谱杀灭病毒细菌 猪流感
图片尺寸750x641
戊二醛癸甲溴铵溶液(普安特)效果怎么样,能治疗宠物环境消毒,猫细菌
图片尺寸790x1279
双链季铵盐络合戊二醛(xd025)
图片尺寸1920x1440
戊二醛2浸泡消毒口腔器械致过敏性休克1例
图片尺寸1080x634
环凯戊二醛检测试纸工厂器械消毒浓度控制残留现场快速检测试剂条
图片尺寸800x800
戊二醛
图片尺寸800x1200
聚维酮碘戊二醛苯扎溴铵复合碘溶液这些水产常用消毒剂全池泼洒给药真
图片尺寸793x550
戊二醛50ar
图片尺寸500x500